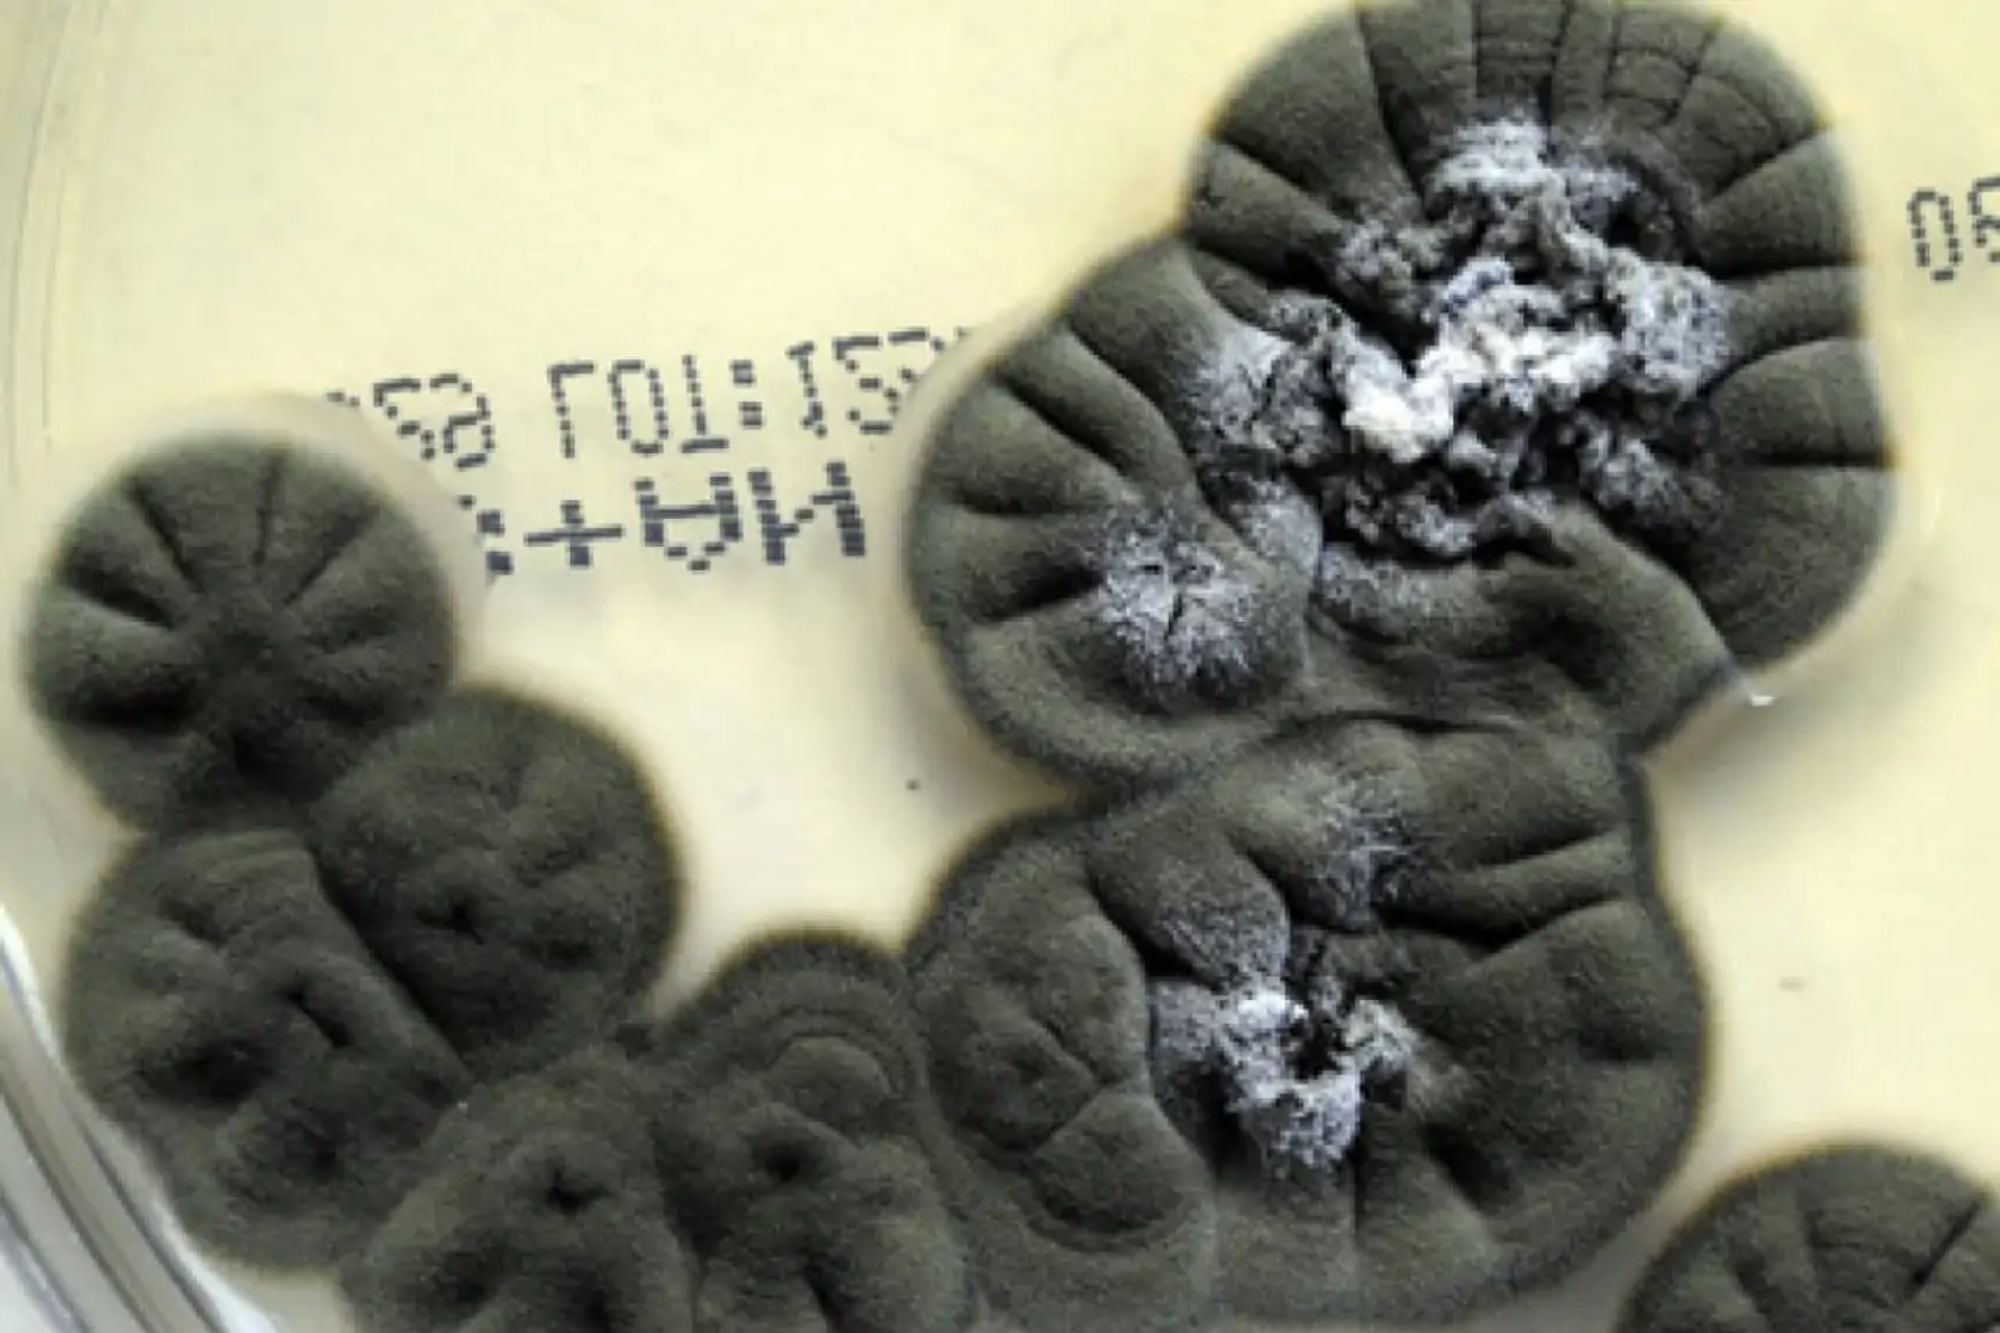
Los hongos negros de Chernóbil que podrían ser clave para futuras misiones espaciales de la NASA

La llegada de las fiestas de Fin de Año suele activar una mezcla particular de emociones. Entre ellas, la nostalgia aparece con fuerza cuando ciertos olores, sonidos o escenas propias de la temporada nos trasladan a momentos pasados.
Según Susan Albers, psicóloga de la Clínica Cleveland, este fenómeno está estrechamente ligado a las tradiciones que repetimos cada año y que evocan recuerdos significativos.

La nostalgia como emoción cálida y familiar
Albers señala que la nostalgia es una emoción asociada a un recuerdo que suele describirse como “agridulce”, porque combina alegría con un sentimiento de añoranza.
De acuerdo con la psicóloga, este tipo de evocaciones puede mejorar el estado de ánimo y ofrecer una pausa frente al estrés que acompaña a las festividades. La especialista indicó que revivir pasatiempos favoritos con seres queridos puede generar una sensación de conexión.
Momentos simples, como disfrutar comidas típicas de esta época o ver una película navideña, suelen activar memorias vívidas, especialmente aquellas vinculadas a la infancia. Por eso, explicó, ciertos platos tradicionales y filmes clásicos resultan reconfortantes año tras año.
Cuando la nostalgia adquiere un matiz negativo
Aunque esta emoción puede ser beneficiosa, Albers advirtió que también puede presentar desventajas. “Por otro lado, demasiada nostalgia puede hacerte sentir anclado en el pasado”, dijo.

En esos casos, la añoranza de tradiciones que ya no existen puede generar tristeza o resaltar una sensación de pérdida. “Puede deprimirte y hacerte sentir emocionalmente pesado”, agregó la psicóloga.
Cómo manejar la nostalgia durante las fiestas
Para evitar que estos sentimientos se vuelvan abrumadores, Albers recomendó:
- Enfocarse en el presente para disminuir la carga emocional asociada a los recuerdos.
- Incorporar nuevas tradiciones navideñas que aporten experiencias frescas.
- Equilibrar la memoria afectiva del pasado con vivencias actuales.
- Promover el bienestar emocional mediante prácticas que permitan conectar con el momento presente.
Por Camila Paola Sánchez Fajardo